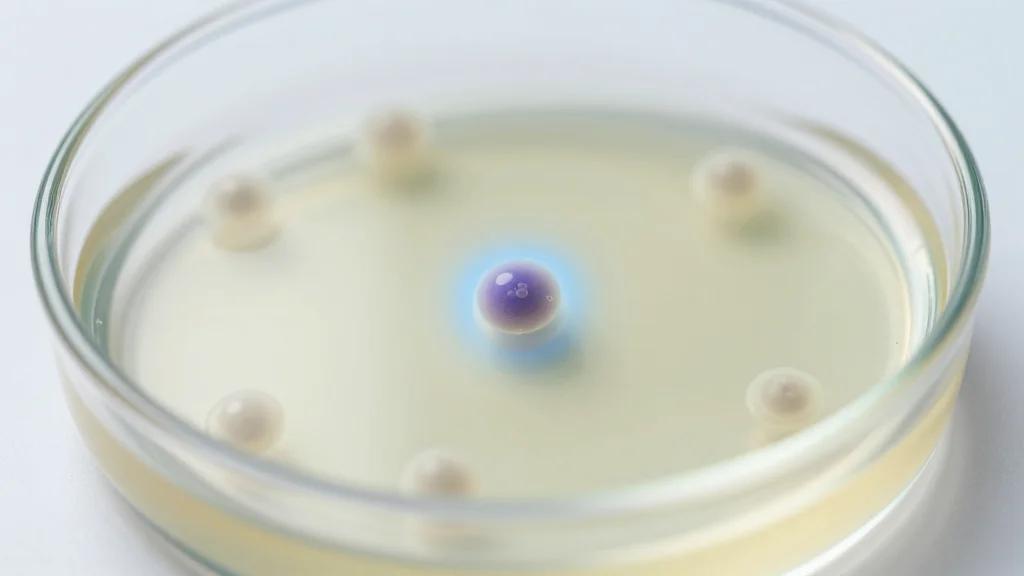
A 'Stemness Checkpoint' Helps Control Stem Cell Identity

Why Inclusive AI Is the Next Frontier of Product Strategy
The article argues that AI product strategy must shift from designing for a vague "average" user to intentionally serving edge users, such as people with disabilities or low digital fluency. Insights from the AI CoCreateSG workshops reveal that current tools assume prompt‑engineering skills, creating barriers for many creators. The author introduces the concept of "AI bilingualists"—users who can translate human ideas into prompts and refine AI output—highlighting the need for tools that teach these skills. Inclusive design is framed as a growth engine, delivering simpler workflows, higher trust, and access to new markets.

Private Energy Partners Submits 780MW Battery Storage Project to Australia’s EPBC Act
Private Energy Partners has lodged an EPBC Act application for a hybrid energy hub in Queensland’s Gladstone State Development Area. The proposal combines a 780 MW lithium‑iron‑phosphate battery storage system—capable of up to eight hours of discharge (6,240 MWh)—with up to 1,188 MW...

Quantum-Secure Satellite Communications and the Future of Protected Networks
Quantum‑secure satellite communications are transitioning from concept to early service architecture, using quantum key distribution from orbit to protect high‑value links. Government programs such as ESA’s SAGA, the QKDSat‑Redwire partnership, and Canada’s QEYSSat illustrate strategic investment driven by sovereignty and...

Coca-Cola’s New Campaign Challenges Japan to Separate the Fizz From the Sizz
Coca‑Cola Japan launched the “Fizz or Sizz” campaign, a sound‑based guessing game that asks consumers to tell whether they hear the fizz of a Coke or the sizzle of karaage. The activation runs for a week across radio, digital out‑of‑home,...

IODM Partners with TransferMate for 283 US University Rollout, Boosts Convera Revenue Share
IODM Ltd announced a partnership with TransferMate to roll out its IODM Connect platform across 283 U.S. universities, using a one‑to‑many implementation model. The company projects onboarding at least five campuses per month in FY 2027 and secured a AUD 1 million, six‑month bridge...

AI Impersonation Is Exposing a Regulatory Gap in Real Estate Platforms
Proptech platforms have accelerated digital real‑estate transactions, but they expose a regulatory blind spot as AI‑driven impersonation scams become more convincing. Cybercriminals use generative AI to forge emails, documents, and voice messages that appear to come from trusted brokers, lawyers,...

Korea OKs First Gen AI-Powered CXR Reporting Tool
South Korea’s Ministry of Food and Drug Safety (MFDS) granted Class III approval to Soombit.ai’s AIRead‑CXR, the nation’s first generative AI‑powered software for draft chest‑X‑ray reporting. The vision‑language model was trained on more than 14 million chest X‑ray studies and can identify...

AI-Enabled Smart Sensor Identifies Fatigue
Researchers at the National University of Singapore unveiled an AI‑enabled smart sensor that detects fatigue with 92% accuracy, a jump from 64% using conventional sensors. The metahydrogel‑based platform combines nanoparticle vibration damping and liquid filtering to deliver an ECG signal‑to‑noise...

Dermal Filler Recently Approved by FDA Could Skew Breast Imaging Results, Experts Warn
The FDA approved Merz Aesthetics' Radiesse dermal filler for use in the décolleté area of adults 22 and older. Radiesse contains hydroxyapatite microspheres that can be visible on medical imaging, raising concerns that it may obscure breast tissue on mammograms....

Evrideo Launches Outpost
Evrideo has launched Outpost, a cloud‑native IP video command centre that consolidates monitoring, routing, recording and stream transformation on standard COTS servers. The solution is offered both as a fully managed SaaS and a self‑hosted licensed deployment, giving broadcasters flexibility...

Space Supply Chain Resilience and Sovereign Industrial Capacity
Space agencies and governments are elevating supply‑chain resilience to a strategic priority, recognizing that mission success hinges on a fragile network of valves, electronics, and specialty materials. NASA’s civil space industrial base assessment and ESA’s industrialisation campaign illustrate a coordinated...

Back to School: Robots Learn From Factory Workers
Czech startup RoboTwin has launched a handheld, no‑code system that lets factory workers teach industrial robots by simply demonstrating a task. The device records human motions and instantly generates robot programmes, cutting setup time to about a minute. Backed by...

TRAI Weighs Direct Satellite-to-Mobile Communication Services
India’s telecom regulator TRAI has issued a consultation paper on Direct‑to‑Device (D2D) satellite services, which would let ordinary mobile phones receive signals directly from satellites. The regulator is weighing two models – using Mobile Satellite Service (MSS) spectrum or repurposing...

EV Chargers To Roll Out Faster Under New Rules
New Zealand has amended the National Environmental Standards for Electricity Transmission Activities (NES‑ETA) to create a single, nationally consistent permitted‑activity framework for electric‑vehicle (EV) charging infrastructure. The new rules, effective 7 May, cover private chargers, corridor sites, chargers attached to other...

CMES Robotics USA and Engineering Innovation to Showcase AI-Powered Parcel Handling Solution at MODEX 2026
CMES Robotics USA and Engineering Innovation are debuting an AI‑powered parcel handling system at MODEX 2026 in Atlanta. The solution combines CMES’s AI Vision piece‑picking technology with EII’s Chameleon® Parcel Sorting System to automate gaylord‑to‑conveyor workflows. Live demos will show...

BitFlow Frame Grabber Selected by NASA for Space Radiation Testing of InGaAs Infrared Camera
BitFlow’s Axion‑CL Camera Link frame grabber was chosen by NASA’s Goddard Space Flight Center as the sole data‑acquisition interface for a rigorous single‑event effects test of Princeton Infrared Technologies’ 1280MVCam InGaAs SWIR camera at the Space Radiation Laboratory. The test...

How VirtueLife Makes Home Physiotherapy Actually Work
VirtueLife, founded in 2023 by Yogesh and Ruby Patel, offers a SaaS platform that lets physiotherapists prescribe video‑guided home exercises from a library of about 2,000 movements. The system uses OpenAI‑powered AI to generate suggested plans, which clinicians must review...

GLP-1 Drugs Shown to Fight Arthritis Independent of Weight Loss
A Chinese study found that semaglutide, a GLP‑1 drug best known for diabetes and weight‑loss treatment, can halt cartilage degradation and even thicken cartilage in osteoarthritis patients, independent of weight loss. In mice, only the semaglutide‑treated group showed reduced joint...

Shaky Ceasefire Unlikely to Stop Cyberattacks From Iran-Linked Hackers for Long
A tentative cease‑fire between Iran, the United States and Israel is unlikely to halt cyber attacks from Iran‑linked groups. Pro‑Iranian hacktivist collective Handala announced it will pause attacks on U.S. targets but continue striking Israel, warning it will resume U.S....

First-of-Its-Kind 24/7 Robotic Kitchen Doubles Peak Dining Capacity at WellSpan York Hospital in Just 400sf
WellSpan Health has launched Fresh Take Eatery, a 400‑sq‑ft AI‑driven robotic kitchen at its York Hospital. The system, built with RoboEatz and ABB Robotics, can operate 24/7, store 80 fresh ingredients and prepare hundreds of customized meals on demand. By...

Fake QR Codes Make for Easy Scams – Be Careful What You Scan Out There
QR codes have become ubiquitous for payments, menus, and transport, but their convenience also makes them a prime vector for scams. Cybercriminals employ "quishing"—QR‑based phishing—to redirect users to counterfeit login or payment sites, often by overlaying fake stickers on legitimate...

Why I Stopped Using 'Modern Standby' On My Windows Laptop to Save Battery Overnight
Microsoft’s Modern Standby puts newer laptops into a low‑power S0 state that keeps limited background tasks alive, promising instant wake‑up. In practice, rogue drivers or apps can prevent a true idle, leaving the machine hot and draining the battery overnight....

Russia's Forest Blizzard Nabs Rafts of Logins Via SOHO Routers
Russian GRU‑backed APT28, also known as Fancy Bear, has been exploiting long‑standing bugs in consumer‑grade SOHO routers such as MikroTik and TP‑Link to intercept web traffic worldwide. By reconfiguring DNS settings on compromised devices, the group silently siphons email credentials and...

Single-Cell Atlas of Maternal–Fetal Interface Sheds Light on Pregnancy Complications
Scientists at UCSF have produced a comprehensive single‑cell atlas of the human maternal–fetal interface, analyzing about 200,000 cells from early gestation to term. The study combined single‑nucleus transcriptomics, chromatin accessibility, spatial transcriptomics and multiplex protein imaging to map cell types...

La Trobe University Researchers Develop Portable PFAS Biosensor
La Trobe University researchers have created a portable biosensor that detects per‑fluorooctanoic acid (PFOA), a key PFAS compound, on site and delivers an instant yes‑or‑no result. The device offers a low‑cost alternative to expensive laboratory analysis, potentially expanding monitoring frequency...

Bronchial Branch Tracing with Cone-Beam CT Tool-in-Lesion Confirmation for Peripheral Pulmonary Nodules
A prospective single‑center study evaluated adding cone‑beam computed tomography (CBCT) to a bronchial branch tracing and radial EBUS workflow for peripheral pulmonary nodules. CBCT‑guided re‑navigation boosted navigational yield from 75% to 90% and raised diagnostic yield to 80%, compared with...

Long-Term Follow-Up Results of Topical Imiquimod for High-Grade Cervical Intraepithelial Neoplasia in Young Women: An Original Research
A retrospective single‑arm cohort studied topical imiquimod in nulliparous women under 35 with CIN 2/3 to avoid cervical excision. After eight weekly applications, 96% of lesions regressed to at least CIN 1 and 47% cleared high‑risk HPV. Long‑term follow‑up showed 81.6% complete...

How David’s Bridal Is Evolving Beyond Traditional Retail
At Shoptalk in Las Vegas, David’s Bridal executives unveiled their "Aisle to Algorithm" strategy, using large language models and the AI‑powered Pearl Planner to streamline internal workflows and personalize the bridal shopping experience. They highlighted how artificial intelligence is reshaping...

AVNT's Growth Catalysts: Defense Capacity and Chip Packaging Tailwinds
Avient Corp (AVNT) is pivoting toward higher‑margin end markets such as defense, healthcare, telecom and chip packaging, with an 8% defense growth in 2025 driving its Specialty Engineered Materials segment. The company is expanding Dyneema capacity through a debottlenecking process...

Stateless Hash-Based Signatures for AI Model Weight Integrity
Enterprises deploying AI agents with Model Context Protocol (MCP) must test cryptographic safeguards in realistic cloud sandboxes. Simulating post‑quantum algorithms such as Kyber and Dilithium on high‑entropy instances reveals significant CPU and latency overhead, especially under heavy agent loads. Proper...

SharkNinja Powers Sales Surge Through Retail Media Campaign via Zitcha and Market Media
SharkNinja partnered with Zitcha and Market Media to run an always‑on retail media campaign across Noel Leeming’s in‑store screens, on‑site displays, EDMs and off‑site social ads. The full‑funnel effort generated more than 830,000 impressions, 6,400 clicks and delivered a return...

Australia Needs to Rapidly Electrify as Much as Possible, as Fast as Possible
A brief cease‑fire between the United States and Iran averted a potential shutdown of the Strait of Hormuz, exposing how fragile global oil supplies are. The episode highlighted the risk of a prolonged Middle‑East production outage, which would strain economies...

Federal Court Denies Anthropic’s Motion to Lift ‘Supply Chain Risk’ Label
A three‑judge panel of the D.C. Circuit denied Anthropic's request to halt the Department of Defense's "supply chain risk" designation, keeping the AI startup on a blacklist that bars it from federal contracts. The judges said Anthropic failed to meet...

OCR Releases Risk Management Video
The U.S. Department of Health and Human Services Office for Civil Rights (OCR) has released a new video that explains the HIPAA Security Rule’s risk‑management requirement. The presentation, led by senior cybersecurity advisor Nicholas Heesters, expands OCR’s earlier Risk Analysis...

Sinch Mailgun Report: Companies Are Leaving Email Performance on the Table
Sinch Mailgun’s Email Impact Report 2026, based on 400 billion emails and a survey of 1,200+ senders, reveals that 18% of messages fail to reach inboxes, jeopardizing up to a fifth of potential ROI. While 78% of respondents deem email critical, only...

China Launches 18 More Qianfan Internet Satellites
China’s Long March 8 rocket lifted off from Wenchang, placing 18 additional Qianfan internet satellites into low‑Earth orbit. The launch brings the total deployed to 137, part of a planned constellation that could eventually host up to 10,000 spacecraft, though the...

Smart Building Technology as a Risk Management Strategy for Food Manufacturers
Smart building technology is emerging as a core risk‑management tool for food manufacturers, converting existing facility data into an early‑warning system that flags equipment strain, environmental shifts, and safety threats before they cause downtime or compliance breaches. The greatest return...

Accounting for Imperfect Displacement in Life Cycle Assessment for Refurbishing and Remanufacturing Operations
A new study proposes endogenizing the displacement rate (DR) in life‑cycle assessment for refurbishing and remanufacturing by modeling firm and customer decisions. The method calculates a market‑driven DR and compares it to a break‑even DR required for net environmental savings....

Not Everyone’s Gone To The Moon
The United States has completed 45 lunar missions—the most of any nation—culminating with the Artemis II launch on April 1, 2026. The former USSR conducted 22 missions between 1959 and 1976, while China has logged ten, including a serendipitous 1997 Hong Kong satellite...

The Free Ticket You Just Got Offered to Mumbrella360 Is Not Legitimate
Mumbrella has warned that a phishing email offering a free ticket to its Mumbrella360 conference is fake. The scam uses the sender name “The Mumbrella Team” and the address messaging-service@post.xero.com, with the subject line “Your Complimentary Mumbrella360 Ticket.” Recipients are...

China-Backed Solar Project Powers up in Laos Amid Iran War Energy Shock
China General Nuclear Power Group has completed a 1‑gigawatt solar farm in northern Laos, the country’s first large‑scale mountainous photovoltaic installation. The plant, equipped with about 2.23 million panels, is linked to the 500‑kilovolt China‑Laos power line and is expected to...
A 'Stemness Checkpoint' Helps Control Stem Cell Identity
Researchers from USC and the NIEHS have identified the protein GSK3α as a universal "stemness checkpoint" that governs differentiation across multiple stem‑cell types. Inhibiting GSK3α allowed mouse embryonic stem cells and epiblast stem cells to retain their distinct identities even...

How to Pay Rent via Bilt Rewards and Earn Points on Your Biggest Monthly Expense
Bilt has revamped its rewards platform with Bilt 2.0, allowing renters to earn loyalty points on housing payments without convenience fees when using a Bilt credit card. For properties in the Bilt Rewards Alliance, rent is paid via ACH in the...

One Woman, Three Autoimmune Diseases: CAR-T Therapy Vanquishes Ultra-Rare Disease Trio
German researchers used a single dose of engineered CAR‑T cells to treat a 47‑year‑old woman suffering from three ultra‑rare autoimmune diseases—autoimmune haemolytic anaemia, immune thrombocytopenia, and antiphospholipid syndrome. After previous failures with steroids and nine other therapies, her own T...

The Cognitive Benefits of Nitrate in Patients with Alcohol Use Disorder: Unraveling the Oral Microbiome Ectopic Colonization Pathway
A 2025 clinical trial found that dietary nitrate supplementation improves cognitive performance in patients with alcohol use disorder (AUD). The benefit was traced to a reshaping of the oral microbiome, which increased nitrate‑reducing bacteria and limited ectopic colonization of oral...

End of the Billable Hour — How AI's Reshaping the Value Model of Ad Agencies
The advertising industry is moving away from the traditional billable‑hour model as generative AI lowers production costs and forces agencies to prove value through outcomes. A World Federation of Advertising study shows 80 % of brands are uneasy about agencies’ AI...

When AI Can Hack Anything, Identity Becomes Everything
Anthropic’s upcoming Claude Mythos model is being touted as far ahead of any existing AI in cyber‑offensive capability, signaling a new wave of tools that can automate vulnerability discovery and exploitation. The more immediate danger, however, is AI‑driven impersonation: 81%...

Diffusion, Not Just Innovation, to Determine AI Impact-
The article argues that AI’s true economic impact will be driven by how widely the technology diffuses, not merely by breakthroughs from the United States or China. While the US and China lead in algorithmic innovation, a broader set of...

Walmart Mexico Expands ESL Partnership
Walmart de México y Centroamérica announced an expansion of its electronic shelf label (ESL) partnership with AI‑digitisation specialist Vusion. The rollout will extend Vusion’s AI‑driven pricing and inventory modules to a larger share of Walmart’s Mexican store network. The collaboration...

#ThisWeek on MarkLives MEDIA: Nick Grubb on Kagiso Connect • #NextWeek: WhatsApp in the Media Mix
Kagiso Connect CEO Nick Grubb announced the company’s strategic move beyond its radio roots into insurance, lifestyle services, and data analytics. The shift reflects broader ad‑spend migration toward diversified, performance‑driven channels. Grubb highlighted that these new verticals will leverage the firm’s...